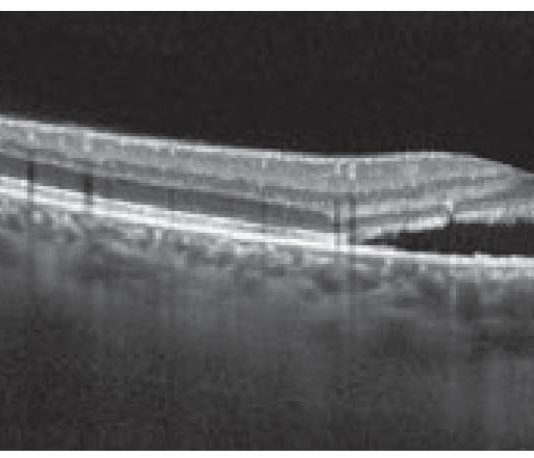

Curcumina: potenziale trattamento adiuvante per le malattie oculari
La curcumina è un pigmento naturale estratto nel 1815 dai rizomi della curcuma longa, una spezia della...
Sindromi masquerades: il linfoma vitreoretinico primario
(Sindromi masquerades) Autore: Chiara Giuffrè
Medico specializzando in oftalmologia, dipartimento di oftalmologia, IRCCS ospedale San Raffaele, Milano
Era il...
Desametasone a lento rilascio per risolvere l’edema maculare cistoide nella malattia...
INTRODUZIONE
Negli ultimi anni, l’utilizzo degli steroidi intravitreali a lento rilascio ha permesso di ottenere ottimi risultati anatomici...
Retinografia wide-field nelle degenerazioni retiniche periferiche
La diagnosi precoce e l’eventuale trattamento tempestivo delle degenerazioni retiniche periferiche regmatogene è una delle competenze spesso...
Acute macular neuroretinopathy e paracentral acute middle maculopathy
La Acute Macular Neuroretinopathy (AMN) e la Paracentral Acute Middle Maculopathy (PAMM) sono condizioni retiniche caratterizzate da...
Valutazione del discomfort oculare da dry-eye nei videoterminalisti
Introduzione
Con il rapido incremento nell’uso dei dispositivi digitali (computer, tablet, smartphone, ecc.) nella popolazione generale, un numero...
Impianto di IOL multifocali a fissazione sclerale in bambini affetti da...
INTRODUZIONE
L’Ectopia Lentis, definita come dislocazione o spostamento del cristallino, è una condizione classificata in letteratura come congenita,...
Analisi morfo-funzionale delle ghiandole di Meibomio e correlazione con livelli plasmatici...
La MGD (meibomian gland disease) è la causa più comune della sindrome dell’occhio secco evaporativo (1). Esiste...
Angio OCT senza iniezione di colorante
Una nuova era per la diagnostica delle malattie corioretinitiche
Era il 1975 quando la fluorangiografia (FAG) rivoluzionava la pratica...
L’imaging Ultra-Wide-Field (UWF) nella diagnosi e nella stadiazione della retinopatia diabetica
Riassunto
L'angiografia con fluoresceina (FA) è fondamentale per valutare le aree ischemiche, le anomalie microvascolari intraretiniche e le...